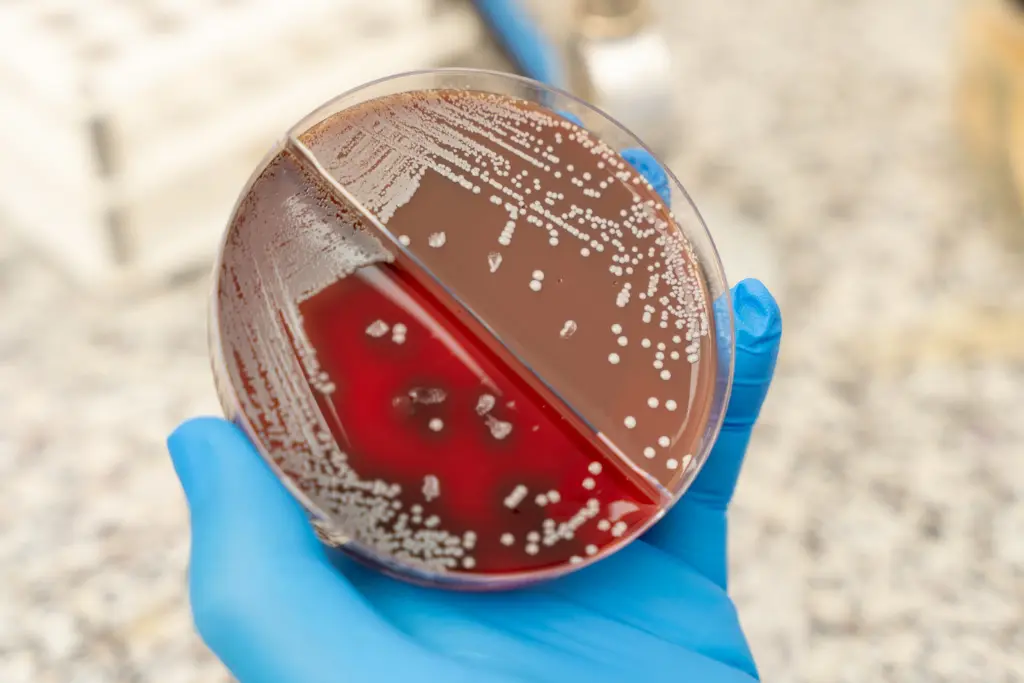
microbiología laboratorio clinico cabrera

Explora nuestra amplia gama de servicios de análisis clínico en Laboratorio Clínico Cabrera. Garantizamos análisis precisos y rápidos respaldados por tecnología avanzada. Incluimos análisis de sangre, orina, diagnóstico molecular y más. Confía en nosotros para tu bienestar.
En Laboratorio Clínico Cabrera, estamos orgullosos de contar con un sistema totalmente automatizado en nuestros equipos Biolis 30i y Dirui. Estos avanzados sistemas nos permiten procesar una amplia gama de análisis clínicos con eficiencia y precisión. Desde perfiles lipídicos y renales hasta pruebas reumatológicas y hepáticas, nuestro sistema automatizado garantiza resultados confiables y rápidos.


Contamos con el equipo Cobas e411, una herramienta totalmente automatizada que realiza una amplia variedad de pruebas hormonales, alérgicas y marcadores tumorales. Este equipo de última generación ofrece resultados precisos y rápidos, proporcionando información vital para el diagnóstico y manejo de diversas condiciones médicas.


Estamos equipados con el innovador equipo Mythic 22, diseñado para realizar hemogramas completos con hasta 22 parámetros diferentes. Este sistema, totalmente automatizado, nos permite obtener resultados rápidos y confiables sobre diversos aspectos de la sangre de nuestros pacientes.



En Laboratorio Clínico Cabrera, contamos con el avanzado equipo JOKOH automatizado, especializado en la realización de análisis de electrolitos sanguíneos clave, como el Sodio, Potasio y Cloro. Estos electrolitos desempeñan un papel fundamental en el equilibrio y funcionamiento adecuado del cuerpo humano, y su nivel puede ser indicativo de diversas condiciones médicas.


Disponemos de un lector de Elisa altamente especializado para la detección cuantificada del Helicobacter Pylori en muestras de heces. Este método de análisis es fundamental en el diagnóstico de infecciones por H. pylori, una bacteria asociada a diversas condiciones gastrointestinales, como úlceras gástricas y gastritis crónica.

Hemos implementado un sistema de laboratorio innovador que utiliza códigos de barras para la identificación de muestras. Cada muestra recibida en nuestro laboratorio es asignada con un código de barras único, lo que nos permite rastrear y gestionar eficientemente el procesamiento de las muestras.


En Laboratorio Clínico Cabrera, nuestra sección de microbiología ofrece una amplia gama de servicios especializados para el diagnóstico y tratamiento de enfermedades infecciosas. Contamos con un equipo de expertos altamente capacitados y tecnología de vanguardia para realizar todo tipo de cultivos microbiológicos.

Nos esforzamos por garantizar la comodidad y precisión en la toma de muestras de nuestros pacientes. Es por eso que hemos incorporado tecnología avanzada, como el detector de venas, para mejorar la experiencia de la extracción de sangre, especialmente en casos donde las venas son difíciles de visualizar a simple vista.

Solicita nuestro servicio de toma de muestra a domicilio para pacientes que no puedan acudir al Laboratorio por invalidez o tercera edad.

